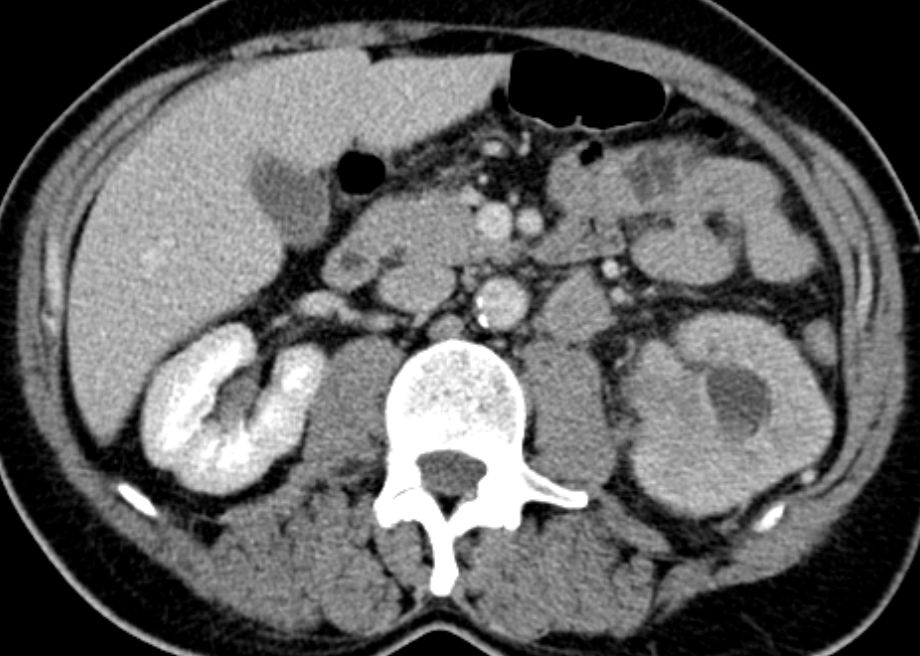

Allgemeines
Gen - Diagnostik



CT
Bei der Durchuntersuchung wurde eine Metastase in BWK5 mit drohendem Querschnitt gefunden.
Es erfolgte eine Laminektomie und Stabilisierung von Pedikelschrauben von T3,4 aud T6,7.
Als Primärtumor wurde ein Nierentumor T3 pN2(4/5) m1oss gefunden.

CT

Quellen
Diagnostic accuracy of computed tomography-guided percutaneous biopsy of renal masses.
Eur Urol 53(2008):1003-11
2.) Lechevallier E, et al.:
Fine-needle percutaneous biopsy of renal masses with helical CT guidance.
Radiology 216(2000):506-10
3.) Neuzillet Y, et al.:
Accuracy and clinical role of fine needle percutaneous biopsy with computerized tomography guidance of small (less than 4.0 cm) renal masses.
J Urol 171(2004):1802-5
